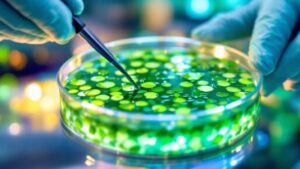
cultivating plant cells methodically

Blog
- Photoperiodism in Plants
 You’ll be amazed at how plants tell time without a clock, using day length to trigger crucial life events.
You’ll be amazed at how plants tell time without a clock, using day length to trigger crucial life events. - Inflorescence Patterns
 Stunning flower arrangements in nature serve a purpose. Discover the secrets behind inflorescence patterns and why they matter…
Stunning flower arrangements in nature serve a purpose. Discover the secrets behind inflorescence patterns and why they matter… - Nitrogen Fixation Process
 Grasping the nitrogen fixation process reveals nature’s ingenuity, but its industrial counterpart raises environmental concerns. What’s the true cost of our fertilizer dependence?
Grasping the nitrogen fixation process reveals nature’s ingenuity, but its industrial counterpart raises environmental concerns. What’s the true cost of our fertilizer dependence? - Bacterial Transformation Steps
 Wondering how to introduce foreign DNA into bacteria? Discover the essential steps for bacterial transformation, from competent cell preparation to gene expression. But there’s a crucial twist…
Wondering how to introduce foreign DNA into bacteria? Discover the essential steps for bacterial transformation, from competent cell preparation to gene expression. But there’s a crucial twist… - Gram Staining Procedure
 Curious about Gram staining? This crucial microbiology technique differentiates bacteria, but mastering it requires precise steps and…
Curious about Gram staining? This crucial microbiology technique differentiates bacteria, but mastering it requires precise steps and… - Bacterial Colony Morphology Types
 From circular to rhizoid, bacterial colony shapes offer crucial clues about microbial species, but there’s more to discover…
From circular to rhizoid, bacterial colony shapes offer crucial clues about microbial species, but there’s more to discover… - Zoology Research Methods
 Hunting for insights into animal behavior? Zoology research methods offer a diverse toolkit, from field observations to DNA analysis, but there’s more…
Hunting for insights into animal behavior? Zoology research methods offer a diverse toolkit, from field observations to DNA analysis, but there’s more… - Bacterial Growth Curve Phases
 Delve into the dynamic world of bacterial growth curves, where four distinct phases reveal surprising survival strategies and…
Delve into the dynamic world of bacterial growth curves, where four distinct phases reveal surprising survival strategies and… - Allelopathy Examples
 Curious about plants waging chemical warfare? Discover diverse allelopathy examples from forests to farms, revealing nature’s hidden battles and their far-reaching impacts.
Curious about plants waging chemical warfare? Discover diverse allelopathy examples from forests to farms, revealing nature’s hidden battles and their far-reaching impacts. - Seed Dormancy Mechanisms
 Obscure yet vital, seed dormancy mechanisms control when plants awaken. What hidden forces determine a seed’s fate? Discover nature’s ingenious survival strategies…
Obscure yet vital, seed dormancy mechanisms control when plants awaken. What hidden forces determine a seed’s fate? Discover nature’s ingenious survival strategies… - Plant Tissue Culture
Cultivating plants in sterile labs revolutionizes agriculture, but what hidden potential lies within these tiny tissue cultures?
Cultivating plants in sterile labs revolutionizes agriculture, but what hidden potential lies within these tiny tissue cultures? - Ethnobotany Applications
 Once overlooked, ethnobotany now revolutionizes industries from medicine to agriculture, but its most groundbreaking applications may still be…
Once overlooked, ethnobotany now revolutionizes industries from medicine to agriculture, but its most groundbreaking applications may still be… - Phytoremediation Techniques
 Harnessing nature’s power, phytoremediation techniques offer innovative solutions for cleaning polluted environments, but which method works best for…
Harnessing nature’s power, phytoremediation techniques offer innovative solutions for cleaning polluted environments, but which method works best for… - Hydrophyte Characteristics
 Leaves, roots, and reproduction: hydrophytes possess unique adaptations for aquatic life, but their most intriguing feature…
Leaves, roots, and reproduction: hydrophytes possess unique adaptations for aquatic life, but their most intriguing feature… - Zoology Lab Equipment List
 Unveiling the essential tools for zoological research, this comprehensive list covers everything from microscopes to genetic analyzers—but what’s the most crucial piece?
Unveiling the essential tools for zoological research, this comprehensive list covers everything from microscopes to genetic analyzers—but what’s the most crucial piece? - Invertebrate Classification Guide
 Intriguing invertebrates await discovery in this classification guide, revealing diverse groups from tiny protozoans to complex arthropods. What secrets will you uncover?
Intriguing invertebrates await discovery in this classification guide, revealing diverse groups from tiny protozoans to complex arthropods. What secrets will you uncover? - Plant Growth Regulators
 Hidden within plants, growth regulators orchestrate development with precision—but their potential in agriculture and horticulture is just beginning to unfold.
Hidden within plants, growth regulators orchestrate development with precision—but their potential in agriculture and horticulture is just beginning to unfold. - Photosynthetic Pathways
 Three fascinating paths plants take to harness sunlight: C3, C4, and CAM. The secrets behind their survival strategies will amaze you…
Three fascinating paths plants take to harness sunlight: C3, C4, and CAM. The secrets behind their survival strategies will amaze you… - Zoology Career Paths
 Hoping to work with animals? Zoology offers diverse career paths, from wildlife biology to marine research. But which role suits you best?
Hoping to work with animals? Zoology offers diverse career paths, from wildlife biology to marine research. But which role suits you best? - Animal Behavior Observation
 Discover the secrets of wildlife through expert animal behavior observation techniques. What hidden patterns will you uncover in nature’s tapestry?
Discover the secrets of wildlife through expert animal behavior observation techniques. What hidden patterns will you uncover in nature’s tapestry? - Zoological Nomenclature Rules
 A fascinating system of animal naming awaits, but the rules of zoological nomenclature hold secrets that could change how you view species forever…
A fascinating system of animal naming awaits, but the rules of zoological nomenclature hold secrets that could change how you view species forever… - Animal Adaptation Examples
 From Arctic foxes to deep-sea dwellers, animal adaptations showcase nature’s ingenuity in survival—but which creature’s ability will astound you most?
From Arctic foxes to deep-sea dwellers, animal adaptations showcase nature’s ingenuity in survival—but which creature’s ability will astound you most? - Halophytes Examples
 Known for their salt-loving nature, halophytes like mangroves and sea lavender thrive in harsh environments, but their adaptations go far beyond…
Known for their salt-loving nature, halophytes like mangroves and sea lavender thrive in harsh environments, but their adaptations go far beyond… - Xylem Tissue Structure
 Gaining insight into the intricate structure of xylem, the water-conducting tissue in plants, unveils its remarkable adaptations that enable it to fulfill its essential function.
Gaining insight into the intricate structure of xylem, the water-conducting tissue in plants, unveils its remarkable adaptations that enable it to fulfill its essential function. - Phloem Transport Process
 Navigating the vital phloem transport process, where osmosis-driven pressure gradients propel nutrient-rich sap through the vascular system, unlocking insights into plant health and optimization.
Navigating the vital phloem transport process, where osmosis-driven pressure gradients propel nutrient-rich sap through the vascular system, unlocking insights into plant health and optimization. - Zoology Field Techniques
 Glimpse into the wild world of zoology field techniques, where hidden cameras and DNA samples unveil nature’s secrets. But what…
Glimpse into the wild world of zoology field techniques, where hidden cameras and DNA samples unveil nature’s secrets. But what… - Zoology Dissertation Topics
 Baffling animal behaviors and ecological mysteries await exploration in zoology dissertations, but which topic will captivate your research passion?
Baffling animal behaviors and ecological mysteries await exploration in zoology dissertations, but which topic will captivate your research passion? - Epiphyte Adaptations
 Baffling adaptations allow epiphytes to thrive atop trees, but their most intriguing survival strategy
Baffling adaptations allow epiphytes to thrive atop trees, but their most intriguing survival strategy - Animal Diversity Index
 Nature’s complexity distilled into a single number, the Animal Diversity Index reveals ecosystem health, but what secrets does it hide
Nature’s complexity distilled into a single number, the Animal Diversity Index reveals ecosystem health, but what secrets does it hide - Animal Behavior Theories
 Shedding light on why animals act as they do, animal behavior theories offer diverse perspectives that will leave you
Shedding light on why animals act as they do, animal behavior theories offer diverse perspectives that will leave you - Microbiology Lab Equipment List
 Geared with cutting-edge tools, a microbiology lab’s arsenal extends far beyond microscopes. But what other essential equipment
Geared with cutting-edge tools, a microbiology lab’s arsenal extends far beyond microscopes. But what other essential equipment - Plant Taxonomy for Amateur Botanists
 From leaf arrangements to flower structures, plant taxonomy unlocks the secrets of identification for amateur botanists, but mastering this skill requires…
From leaf arrangements to flower structures, plant taxonomy unlocks the secrets of identification for amateur botanists, but mastering this skill requires… - Leaf Morphology Types
 Grasping the intricacies of leaf morphology types unlocks a world of botanical diversity, but what hidden secrets do these shapes and structures…
Grasping the intricacies of leaf morphology types unlocks a world of botanical diversity, but what hidden secrets do these shapes and structures… - Plant Pigment Types
 What if plant pigments weren’t just about color? Discover the hidden roles of these vibrant compounds in nature’s palette.
What if plant pigments weren’t just about color? Discover the hidden roles of these vibrant compounds in nature’s palette. - Wildlife Conservation Techniques
 Wildlife conservation techniques offer hope for endangered species, but which methods truly make a difference? Discover the surprising answers.
Wildlife conservation techniques offer hope for endangered species, but which methods truly make a difference? Discover the surprising answers. - Avian Digestive System Worksheet
 This worksheet unveils the secrets of avian digestion, from beak to cloaca, but can you master the intricate process
This worksheet unveils the secrets of avian digestion, from beak to cloaca, but can you master the intricate process - Vertebrate Evolution Timeline
 Humans evolved from fish? Discover the astonishing 500-million-year journey of vertebrate evolution, from jawless swimmers to complex land-dwellers.
Humans evolved from fish? Discover the astonishing 500-million-year journey of vertebrate evolution, from jawless swimmers to complex land-dwellers. - Mammalian Endocrine System Chart
 This comprehensive chart unveils the intricate dance of hormones in mammals, but can you spot the hidden connection that
This comprehensive chart unveils the intricate dance of hormones in mammals, but can you spot the hidden connection that - Primate Behavior Observation Techniques
 Groundbreaking primate observation techniques revolutionize our understanding of ape societies, but one controversial method has researchers
Groundbreaking primate observation techniques revolutionize our understanding of ape societies, but one controversial method has researchers - Zoology Careers List
 A diverse world of zoology careers awaits, from animal care to wildlife conservation. Discover which path aligns with your passion for
A diverse world of zoology careers awaits, from animal care to wildlife conservation. Discover which path aligns with your passion for - Mammalogy Lecture Notes
 Captivating mammalogy lecture notes unveil the secrets of diverse mammalian species, from their unique adaptations to their crucial roles in ecosystems, but what about their future?
Captivating mammalogy lecture notes unveil the secrets of diverse mammalian species, from their unique adaptations to their crucial roles in ecosystems, but what about their future? - Bacterial Cell Wall Composition
 Kingdoms of microbes fortified by intricate walls, but what secrets lie within these bacterial barriers? Discover the surprising complexity and crucial importance of
Kingdoms of microbes fortified by intricate walls, but what secrets lie within these bacterial barriers? Discover the surprising complexity and crucial importance of - Basics of Microbiology
 Plunge into the captivating realm of microbiology and unravel the secrets of the microscopic world that profoundly shapes our lives.
Plunge into the captivating realm of microbiology and unravel the secrets of the microscopic world that profoundly shapes our lives. - Evolutionary Biology Concepts
 Natural selection and genetic drift are just the beginning. Delve deeper into evolutionary biology concepts to uncover…
Natural selection and genetic drift are just the beginning. Delve deeper into evolutionary biology concepts to uncover… - Zoology Field Techniques
 Powerful zoology field techniques unlock secrets of wild animals, but which method reveals the most about their hidden lives?
Powerful zoology field techniques unlock secrets of wild animals, but which method reveals the most about their hidden lives? - Antibiotic Sensitivity Test Procedure
 Intriguing and vital, antibiotic sensitivity tests reveal which drugs can defeat bacterial foes, but the procedure’s complexity may surprise
Intriguing and vital, antibiotic sensitivity tests reveal which drugs can defeat bacterial foes, but the procedure’s complexity may surprise - Microbiology Staining Techniques
 Techniques in microbiology staining unveil a hidden world of microbes, but which method reveals the most crucial details? Discover the key
Techniques in microbiology staining unveil a hidden world of microbes, but which method reveals the most crucial details? Discover the key - 12 Best Herpetology Textbooks for Aspiring Reptile and Amphibian Experts
 Mesmerizing secrets of reptiles and amphibians await in these top herpetology textbooks, but which one will unlock your true potential as an expert?
Mesmerizing secrets of reptiles and amphibians await in these top herpetology textbooks, but which one will unlock your true potential as an expert? - 15 Best Zoology Textbooks for Aspiring Animal Scientists in 2024
 Hunting for the perfect zoology textbooks? Discover our curated list of 15 top-tier resources that will elevate your animal science studies in 2024.
Hunting for the perfect zoology textbooks? Discover our curated list of 15 top-tier resources that will elevate your animal science studies in 2024. - 11 Best Botany Textbooks for Budding Plant Enthusiasts in 2024
 Plant lovers, prepare to be amazed! Discover the 11 best botany textbooks of 2024 that will transform your green thumb into a
Plant lovers, prepare to be amazed! Discover the 11 best botany textbooks of 2024 that will transform your green thumb into a - 14 Essential Herpetology Field Guides for Amateur and Pro Reptile Enthusiasts
 Learn about the top 14 herpetology field guides for reptile lovers, from beginner-friendly to expert-level resources. Which one will become your go-to companion?
Learn about the top 14 herpetology field guides for reptile lovers, from beginner-friendly to expert-level resources. Which one will become your go-to companion? - 12 Best Microbiology Textbooks for Aspiring Scientists in 2025
 Unveiling the top 12 microbiology textbooks for 2024, this guide helps aspiring scientists choose resources that will…
Unveiling the top 12 microbiology textbooks for 2024, this guide helps aspiring scientists choose resources that will… - Introduction to Microbial Growth Media Preparation
 Harnessing the power of microbial growth media preparation requires careful selection of ingredients and sterilization methods to cultivate thriving cultures.
Harnessing the power of microbial growth media preparation requires careful selection of ingredients and sterilization methods to cultivate thriving cultures. - Environmental Impact Assessment Report
 Identifying potential environmental consequences, an EIA report is crucial for mitigating ecological damage, but what does the process entail?
Identifying potential environmental consequences, an EIA report is crucial for mitigating ecological damage, but what does the process entail? - EIA Consultancy Services
 Crafting a comprehensive environmental impact assessment is crucial to ensuring project success, but where do you even begin?
Crafting a comprehensive environmental impact assessment is crucial to ensuring project success, but where do you even begin? - Environmental Impact Assessment Methodology
 Mastering environmental impact assessment methodology is crucial to mitigating project risks, but what steps must you take to get it right?
Mastering environmental impact assessment methodology is crucial to mitigating project risks, but what steps must you take to get it right? - EIA for Infrastructure Projects
 Assessing environmental implications, a crucial step in infrastructure project planning, reveals the hidden costs of development and unveils sustainable solutions.
Assessing environmental implications, a crucial step in infrastructure project planning, reveals the hidden costs of development and unveils sustainable solutions. - Environmental Impact Assessment Software
 Cutting-edge EIA software streamlines environmental evaluations, but how can it transform your project's sustainability and decision-making processes?
Cutting-edge EIA software streamlines environmental evaluations, but how can it transform your project's sustainability and decision-making processes? - Aseptic Techniques in Microbiology for Beginners
 Take the first step into the world of microbiology, where aseptic techniques hold the key to unlocking precise and reliable results.
Take the first step into the world of microbiology, where aseptic techniques hold the key to unlocking precise and reliable results. - How to Use a Microscope in Microbiology
 Focus on the fascinating world of microbiology by mastering microscope techniques to uncover the secrets of microorganisms.
Focus on the fascinating world of microbiology by mastering microscope techniques to uncover the secrets of microorganisms. - Beginner's Guide to Gram Staining
 Journey into the world of microbiology and uncover the secrets of Gram staining, a fundamental technique for identifying bacteria.
Journey into the world of microbiology and uncover the secrets of Gram staining, a fundamental technique for identifying bacteria. - Introduction to Microbial Culture Techniques
 Witness the mighty microbes up close as we delve into the fascinating world of microbial culture techniques, where breakthroughs await.
Witness the mighty microbes up close as we delve into the fascinating world of microbial culture techniques, where breakthroughs await. - Basic Microbiology Lab Techniques for Beginners
 Harnessing the secrets of microbiology starts with mastering the fundamentals of aseptic technique, agar plate preparation, and molecular identification methods.
Harnessing the secrets of microbiology starts with mastering the fundamentals of aseptic technique, agar plate preparation, and molecular identification methods. - Parts of a Microscope With Functions and Diagram
 Are you ready to take a closer look at the inner workings of a microscope? Well, hold onto your lab coat because we’re about to …
Are you ready to take a closer look at the inner workings of a microscope? Well, hold onto your lab coat because we’re about to …Parts of a Microscope With Functions and Diagram Read More »
- Animal Cell Structure
 Did you know that the average animal cell is only about 10 to 30 micrometers in size? That’s smaller than the width of a human …
Did you know that the average animal cell is only about 10 to 30 micrometers in size? That’s smaller than the width of a human … - Plant Cell Structure
 Have you ever stopped to marvel at the intricate design of a plant? Well, brace yourself for an even more astonishing revelation – the structure …
Have you ever stopped to marvel at the intricate design of a plant? Well, brace yourself for an even more astonishing revelation – the structure … - Abiotic Factors- Definition, Types, Examples and Responses
 Are you aware of the invisible forces that shape the world around us? Picture a dense forest teeming with life, where sunlight filters through the …
Are you aware of the invisible forces that shape the world around us? Picture a dense forest teeming with life, where sunlight filters through the …Abiotic Factors- Definition, Types, Examples and Responses Read More »
- Taproot Vs. Fibrous Root: Key Differences, Examples
 Imagine you’re standing in a lush garden, surrounded by a variety of plants. As you observe their roots, you notice that some plants have thick, …
Imagine you’re standing in a lush garden, surrounded by a variety of plants. As you observe their roots, you notice that some plants have thick, …Taproot Vs. Fibrous Root: Key Differences, Examples Read More »
- Light Microscope- Definition, Principle, Types, Parts
 Are you ready to embark on a journey of discovery, as we shine a light on the fascinating world that can be unveiled through a …
Are you ready to embark on a journey of discovery, as we shine a light on the fascinating world that can be unveiled through a …Light Microscope- Definition, Principle, Types, Parts Read More »
- Celsius Vs. Fahrenheit Scale- Differences With Examples
 Are you tired of the constant debate between the Celsius and Fahrenheit scales? It’s time to settle the score once and for all and finally …
Are you tired of the constant debate between the Celsius and Fahrenheit scales? It’s time to settle the score once and for all and finally …Celsius Vs. Fahrenheit Scale- Differences With Examples Read More »
- The Wobble Hypothesis: Definition, Statement, Significance
 Are you ready to embark on a journey into the captivating world of the Wobble Hypothesis? Just like a hidden treasure waiting to be discovered, …
Are you ready to embark on a journey into the captivating world of the Wobble Hypothesis? Just like a hidden treasure waiting to be discovered, …The Wobble Hypothesis: Definition, Statement, Significance Read More »
- Laboratory Safety Symbols, Signs, and Meanings
 Are you ready to unlock the secret language of laboratory safety? Picture yourself as a detective, deciphering hidden messages that hold the key to a …
Are you ready to unlock the secret language of laboratory safety? Picture yourself as a detective, deciphering hidden messages that hold the key to a … - Photosynthesis Process
 As you step outside on a sunny day, have you ever wondered how plants are able to harness the power of sunlight to produce energy? …
As you step outside on a sunny day, have you ever wondered how plants are able to harness the power of sunlight to produce energy? … - E. Coli (Escherichia Coli)- an Overview
 Have you ever wondered about the mysterious and captivating world of E. coli? Prepare to be amazed as we take you on a journey through …
Have you ever wondered about the mysterious and captivating world of E. coli? Prepare to be amazed as we take you on a journey through … - Instruments Used in Microbiology Lab
 Imagine stepping into a microbiology lab, where the air is filled with the faint scent of disinfectant and the hum of machines. As you observe …
Imagine stepping into a microbiology lab, where the air is filled with the faint scent of disinfectant and the hum of machines. As you observe … - Pyramid of Energy- Definition, Levels, Importance, Examples
 Are you aware that only about 10% of the energy from one trophic level is passed on to the next level in an ecosystem? This …
Are you aware that only about 10% of the energy from one trophic level is passed on to the next level in an ecosystem? This …Pyramid of Energy- Definition, Levels, Importance, Examples Read More »
- Definition, Formula, Table, Finding P-value, Significance
 Are you tired of scratching your head in confusion every time someone mentions p-values? Well, fret no more, because in this article, we have got …
Are you tired of scratching your head in confusion every time someone mentions p-values? Well, fret no more, because in this article, we have got …Definition, Formula, Table, Finding P-value, Significance Read More »
- Krebs Cycle: Location, Enzymes, Steps, Products, Diagram
 Brace yourself for a journey through the intricate pathways of energy production, as we explore the location, enzymes, steps, products, and even a diagram of …
Brace yourself for a journey through the intricate pathways of energy production, as we explore the location, enzymes, steps, products, and even a diagram of …Krebs Cycle: Location, Enzymes, Steps, Products, Diagram Read More »
- Analogous Structures: Definition, Examples, Significances
 Did you know that despite the vast diversity of life on Earth, there are numerous instances where different species have evolved similar structures to perform …
Did you know that despite the vast diversity of life on Earth, there are numerous instances where different species have evolved similar structures to perform …Analogous Structures: Definition, Examples, Significances Read More »
- Thioglycollate Broth- Composition, Principle, Preparation
 So, you think you know all there is to know about microbiology, huh? Well, brace yourself, because we’re about to uncover the fascinating world of …
So, you think you know all there is to know about microbiology, huh? Well, brace yourself, because we’re about to uncover the fascinating world of …Thioglycollate Broth- Composition, Principle, Preparation Read More »
- Vacuoles- Definition, Structure, Types, Functions
 Step into the world of these captivating organelles as we explore their definition, structure, types, and functions. From plant cells to fungi and protists, vacuoles …
Step into the world of these captivating organelles as we explore their definition, structure, types, and functions. From plant cells to fungi and protists, vacuoles …Vacuoles- Definition, Structure, Types, Functions Read More »
- Biuret Test for Protein- Principle, Procedure, Results, Uses
 Imagine yourself in a laboratory, carefully pipetting solutions and observing a mesmerizing transformation of colors. The Biuret Test for Protein is a fascinating biochemical test …
Imagine yourself in a laboratory, carefully pipetting solutions and observing a mesmerizing transformation of colors. The Biuret Test for Protein is a fascinating biochemical test …Biuret Test for Protein- Principle, Procedure, Results, Uses Read More »
- Monocot Vs. Dicot Seed Comparison
 By chance, have you ever wondered about the contrasting features between monocot and dicot seeds? Well, in this discussion, we will uncover the fascinating details …
By chance, have you ever wondered about the contrasting features between monocot and dicot seeds? Well, in this discussion, we will uncover the fascinating details … - Vascular Vs. Non-Vascular Plants
 Are you ready to embark on a fascinating journey into the world of plants, where the battle between vascular and non-vascular species unfolds? As you …
Are you ready to embark on a fascinating journey into the world of plants, where the battle between vascular and non-vascular species unfolds? As you … - Decomposers- Definition, Types, Examples, Decomposition
 As you venture into the intricate world of decomposers, prepare to uncover the hidden champions that silently orchestrate the cycle of life. These remarkable organisms …
As you venture into the intricate world of decomposers, prepare to uncover the hidden champions that silently orchestrate the cycle of life. These remarkable organisms …Decomposers- Definition, Types, Examples, Decomposition Read More »
- Plant Cell Vs. Animal Cell Major Differences
 Are you ready to take a deep dive into the intricate world of cells? Just as two sides of a coin, plant cells and animal …
Are you ready to take a deep dive into the intricate world of cells? Just as two sides of a coin, plant cells and animal … - Eubacteria- Definition, Characteristics, Structure, Types, …
 Are you ready to unlock the doorway to the hidden world of Eubacteria? Prepare to step into a realm where microscopic organisms reign supreme, their …
Are you ready to unlock the doorway to the hidden world of Eubacteria? Prepare to step into a realm where microscopic organisms reign supreme, their …Eubacteria- Definition, Characteristics, Structure, Types, … Read More »
- Streak Plate Method- Principle, Types, Methods, Uses
 Have you ever wondered how microbiologists are able to isolate and study pure cultures of bacteria and yeasts? Well, one theory suggests that the streak …
Have you ever wondered how microbiologists are able to isolate and study pure cultures of bacteria and yeasts? Well, one theory suggests that the streak …Streak Plate Method- Principle, Types, Methods, Uses Read More »
- Biotic Factors explained
 Are you aware of the intricate dance of life that occurs within ecosystems? It’s fascinating to discover how different organisms interact with one another and …
Are you aware of the intricate dance of life that occurs within ecosystems? It’s fascinating to discover how different organisms interact with one another and … - Voluntary Vs. Involuntary Muscles
 Are you curious about the intricate workings of your body? Well, let’s start with a real-life example. Imagine you’re lifting a heavy box, feeling the …
Are you curious about the intricate workings of your body? Well, let’s start with a real-life example. Imagine you’re lifting a heavy box, feeling the … - Cold-Blooded Vs. Warm-Blooded AnimalsCurious about the contrasting characteristics of cold-blooded and warm-blooded animals? Delve into the world of these fascinating creatures and uncover the sixteen key differences that …
- HPLC: Principle, Parts, Types, Uses, Diagram
 Are you curious about the inner workings of High Performance Liquid Chromatography (HPLC)? Well, get ready to uncover the principle, parts, types, uses, and even …
Are you curious about the inner workings of High Performance Liquid Chromatography (HPLC)? Well, get ready to uncover the principle, parts, types, uses, and even … - Characteristics of Threatened Species
 Although a large number of factors can make a species vulnerable to extinction, conservation biologists have observed that the species most vulnerable to extinction belong …
Although a large number of factors can make a species vulnerable to extinction, conservation biologists have observed that the species most vulnerable to extinction belong … - What does genetic drift cause?
 Define genetic drift in biology In wild populations, there are always relatively common and relatively rare alleles. Small populations are at risk of losing genetic …
Define genetic drift in biology In wild populations, there are always relatively common and relatively rare alleles. Small populations are at risk of losing genetic … - Demographic and environmental stochasticity
 Demographic stochasticity Population stochasticity (also known as demographic change) refers to random variations in the demographic characteristics of a population (eg. sex ratios, birth rate, …
Demographic stochasticity Population stochasticity (also known as demographic change) refers to random variations in the demographic characteristics of a population (eg. sex ratios, birth rate, … - What is population bottleneck?
 In some taxa, such as butterflies, annuals, and amphibians, population size varies dramatically from generation to generation. In recent years, populations may be so large …
In some taxa, such as butterflies, annuals, and amphibians, population size varies dramatically from generation to generation. In recent years, populations may be so large … - What causes outbreeding depression?
 Large populations have many ecological, behavioral, and physiological mechanisms that prevent hybridization, the production of offspring among genetically distant taxa, whether they be individuals of …
Large populations have many ecological, behavioral, and physiological mechanisms that prevent hybridization, the production of offspring among genetically distant taxa, whether they be individuals of … - Heterosis and inbreeding depression
 Mating among closely related individuals, which occurs in small populations, often results in lower reproductivesuccess and weaker offspring. In large populations, a variety of instinctive …
Mating among closely related individuals, which occurs in small populations, often results in lower reproductivesuccess and weaker offspring. In large populations, a variety of instinctive … - What is thermal pollution and what causes it?
 Thermal pollution describes localized human-induced temperature changes in the natural world. Aquatic ecosystems represent one of the ecosystems most vulnerable to thermal pollution. For example, …
Thermal pollution describes localized human-induced temperature changes in the natural world. Aquatic ecosystems represent one of the ecosystems most vulnerable to thermal pollution. For example, … - Essay about noise pollution
 Many people find a sense of freedom when they are in natural surroundings, with peace and quiet facilitating a much-needed connection to nature. These experiences …
Many people find a sense of freedom when they are in natural surroundings, with peace and quiet facilitating a much-needed connection to nature. These experiences …
